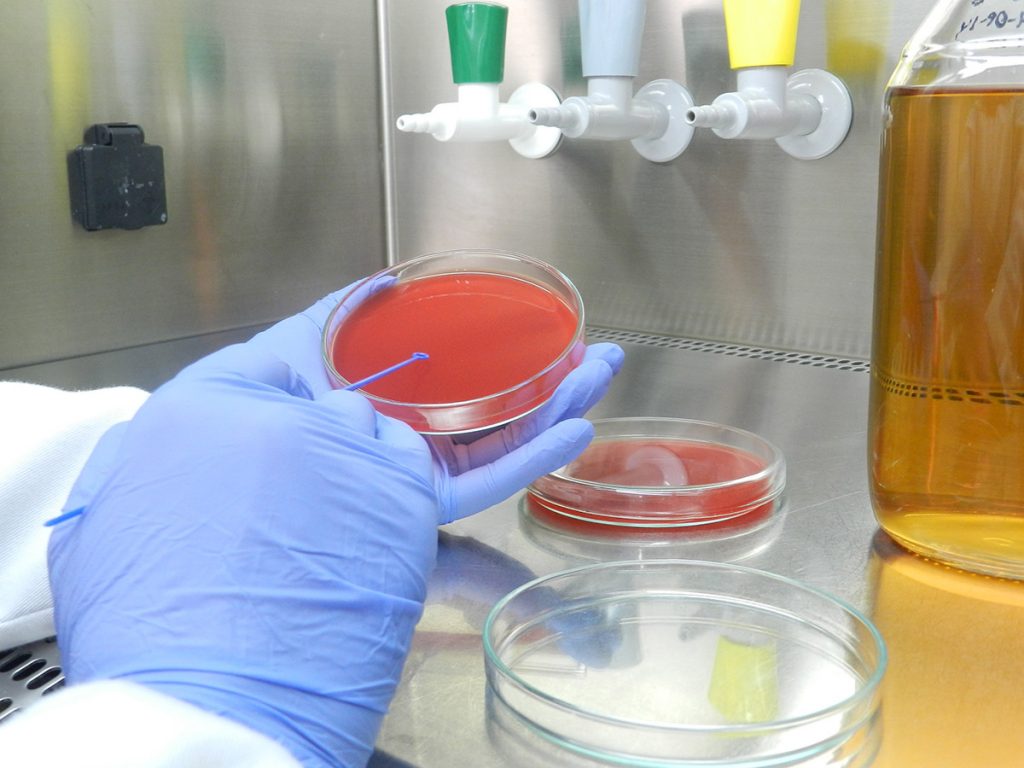

LABORATORIO BIOANÁLISIS SPA. , ofrece servicios de análisis microbiológico de ALIMENTOS y AGUAS, basándonos en la necesidad de demostrar la inocuidad de materias primas y productos terminados y así dar cumplimiento a las especificaciones según autoridades reglamentarias y mercados de destino.
ENTRE LOS SERVICIOS QUE SE OFRECEN SE DESTACAN:
- Análisis Microbiológicos de Alimentos de consumo Humano , Animal y productos Hidrobiológicos.
- Determinación de Listeria monocytogenes por Técnica VIDAS LMOII
- Determinación de Salmonella por Técnica VIDAS
- Análisis Microbiológicos para Aguas
- Control de Calidad Físico- Químico y Organoléptico para Aguas
- Control de Calidad Microbiológico de Superficies, Control de Ambiente y Manipuladores mediante Técnica Petrifilm y VIDAS
- Servicio de Toma de Muestras
- Capacitación a Manipuladores de Alimentos